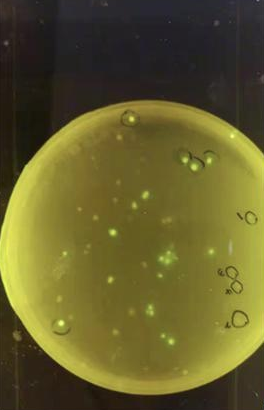

用有颜色的大肠杆菌绘画。

大肠杆菌绘画作品。
表达有颜色的大肠杆菌培养基。
Yucai_SZ团队8名队员。本版图片均由受访单位提供
读特客户端·深圳新闻网2021年12月7日讯(深圳晚报记者 王宇)反手拨弦自在弹,盛唐流韵袅千年。莫高窟壁飞天舞,今献西安贵胄看。敦煌飞天壁画美轮美奂,然而,随着岁月流逝,许多壁画出现了损毁、消失的问题。如何用现代科技方法,修复传统文化瑰宝?深圳8名学子创新尝试,试图寻找一种解决方案。
“与传统方法相比,我们使用大肠杆菌来修复壁画更加精确、高效,并且可以在一个相对较大的范围内实现壁画修复。”12月6日,记者从蛇口育才教育集团育才中学获悉,该校Yucai_SZ团队近日以“用合成生物学的方式修复壁画”项目,摘得生命科学领域世界规模最大、学术影响力最高的国际赛事——2021年iGEM国际的银奖。该比赛以“合成生物学”为主题,鼓励全世界有志于在生命科学领域开拓创新的年轻人,设计完成合成生物学科研项目,尝试解决世界面临的现实问题。
1
队员创新尝试借助合成生物学修复敦煌壁画
Yucai_SZ团队由8名队员组成,他们分别是队长王睿、队员李梓华、李泽均、叶翀睿、王海心、白妍诺、朱子晴、聂一鸣,他们的队伍人数并不多,但一点也不影响他们的参赛热情和信心。
用大肠杆菌修复敦煌壁画,这一大胆的想法是在Yucai_SZ团队大量查阅资料后获得的。今年6月初,团队组建完成后,查阅了大量的相关资料,在看到一篇利用大肠杆菌生成的生物膜矿化之后来修复建筑材料的论文后,对敦煌壁画十分感兴趣的队员白妍诺大胆提出,“我们可以尝试利用大肠杆菌来修复敦煌壁画呀!”
队长王睿说:“敦煌壁画作为世界文化瑰宝,现在正面临着掉色、脱落等问题。作为青年学子,我们希望为修复壁画这项事业献出自己的一份力。”队员王海心表示,团队想尝试用合成生物学这种现代科技的方法修复传统的壁画,将传统文化一直传承下去。
在确定了研究项目之后,团队成员紧锣密鼓地“开干”了!队员李泽均介绍,整个实验有三个部分:融合蛋白表达系统实验、光感受器系统实验以及共转表达。而在修复的过程则主要分为5个部分:将含有大肠杆菌的生物膜转变为凝胶,并将其混合到水凝胶中;将整个水凝胶贴在待修复的墙上;在生物膜形成后喷洒SBF(模拟体液),并等待其矿化;待矿化完成后,将水凝胶掀开;干燥并杀死剩余的细菌。
团队指导老师黄俊芳表示,团队希望利用光控的矿化生物膜生成壁画修复层,再通过精确地控制光照区域,从而精确控制修复层形状。由于光照区域可以通过光学投影和数字化技术精确控制,所以这项技术应用后有望提供一套标准化流程的生物学修复方案,降低壁画修复的人才门槛并大大缩短修复人才的培养周期,“传统壁画修复耗时长,成本大,而我们使用大肠杆菌来修复壁画将会更加精确和高效,并且可以在一个相对较大的范围内实现壁画修复。”
2
暑假期间每天“泡”在实验室
此次比赛周期历时6个月,参赛团队需要利用课余时间,阅读专业文献,查找大量资料,完成项目设计细化每一个细节。在暑假,还要学习实验技能,完成实验室内的研究工作。由于合成生物学具有较强的学科交叉性,参赛项目往往还包含数学建模的内容。
iGEM赛制要求参赛团队设计和进行相关的社会实践,探寻考察可能影响项目技术设计和使用的各类实际因素。最后,团队还要完成项目的英文书写,以及项目网站编写的工作。
回想起为比赛奔忙的日子,王睿十分感慨。育才教育集团三楼的“未来生物实验室”见证了8名队员的泪水和汗水。暑假时,团员每天都“泡”在实验室里做实验。开学后,几乎每隔一天就去一趟实验室,摆弄着各种试管、培养皿。
实验中,生物膜的矿化是后续得以成功的关键,每一个队员都对矿化结果非常期待。矿化的过程需要一周时间,队员们每两天就去实验室给培养基换一次SBF模拟体液。当王睿拿到扫描出来的生物膜电镜照片的那一刻时,团队所有人都非常激动,争着挤着想要拿上照片细细端详。王睿回忆,后来,成员们拿着照片满实验室蹦跶,跳着、跑着、欢呼着。
3
六位国际评委为育才学子点赞
赛事评委对该项目表达了充分的肯定。一位评委表示:“这种保护壁画的应用想法很有创意。在我看来,生物膜技术在不同行业领域有很大的应用前景,生物膜和壁画之间的相互作用及反应类型用于保护壁画不被损坏,或将产生极大贡献。”另一位赛事评委评价:“这个项目解决了一个不同寻常的问题——恢复古代艺术品,不仅耐人寻味,而且非常酷!作为一个高中生团队,你们完成了大量出色的工作,并且表现出了对合成生物学领域的深入理解……”
为了备战iGEM比赛,团队8名学子前前后后倾情准备了180个日日夜夜。王睿表示,作为队长,最大的收获是感受了“生物”和“研究”的魅力。在艰辛的备战过程中,她也收获到了不少生物乐趣,用有颜色的大肠杆菌画画、用捣毁了的培养基养杂菌……都别有一番乐趣。
队员李泽均认为,iGEM项目对完整度要求高,综合能力需求强。一个项目的顺利完成离不开所有成员的努力付出。在比赛中,他和专业人士沟通,和指导老师交流,不断地学习并提升自己,同时还充分地领略了合成生物学的魅力和广阔前景。队员王海心则认为自己跳出了课本知识之外,体会到了科研项目研究的乐趣。
团队指导老师黄俊芳表示,此次比赛不同于以往的传统学科教学,对于学生来说是一项综合性项目式的学习。在比赛中过程中,他们不仅学习了各项技能,也领悟了团结协作的精神。“接下来,我们会继续完善我们的实验,希望可以在矿化层上呈现有更多种类的颜色,以重现壁画的原貌。我们认为将多色光控彩色蛋白技术与我们的矿化系统组合,将可以实现修复壁画色彩的目的。”

